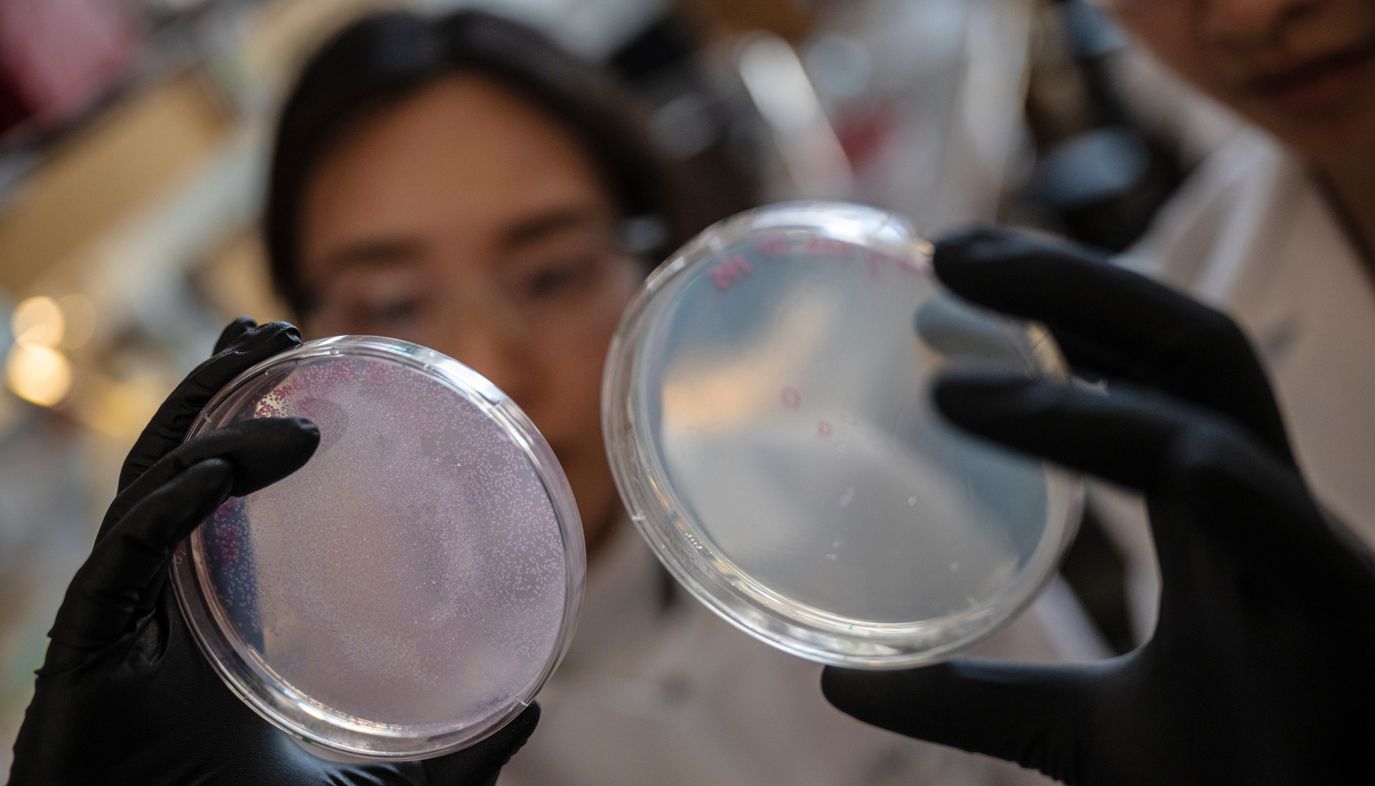

Protect the Future of Discovery
Behind Every Breakthrough
Breakthroughs happen when the drive to improve lives, the spark of discovery is nurtured with a strong foundation of support. With resources, collaboration, and investment to turn possibility into reality. With that support, we’re changing the world, one breakthrough at a time.
Why Funding Matters
The future of research funding lies with Congress. We need your voice to ensure that life-saving discoveries continue, that UC San Diego remains at the forefront of innovation, and that the next generation of scientists has the resources to change the world.
Tell your elected representatives: Protect life-saving discoveries. Protect research funding.

Always moving discovery forward
When research is supported, it becomes real-world progress — turning curiosity into practical solutions that improve health, protect communities and strengthen the systems we all rely on.


The Future of Health
From your medicine cabinet to your bedside to high-tech research labs, we’re advancing health in ways that you can count on.

Empowered Communities
We’re pioneering technology that keeps you and your family safe, developing programs that prepare future workforces and enabling startups to turn new ideas into real-world situations.

Transformative Tech
We’re leading advancements in technology, artificial intelligence, manufacturing and beyond to put new solutions in your hands, in your community and in your future.
Stand Up for UC Research
The suspension of federal research funding threatens life-saving discoveries, slows innovation, and limits opportunities across the University of California — including right here at UC San Diego.
We need your voice. The future of research at UC — and the breakthroughs that change lives — is at stake. Together, we can stand up for UC San Diego and all of UC.
Help Fuel the Future
Every day, UC San Diego researchers and physician-scientists are making breakthroughs in cancer therapies; policy experts are driving initiatives that protect our food chain, safety and health; and innovators and entrepreneurs are fueling our economic growth. As our campus — and our nation — face unprecedented challenges to this transformative work, your philanthropy has the potential to make a critical difference for the discoveries that drive us forward.

What Fuels Breakthroughs?
Federal funding fuels discoveries that don’t stop at the lab—they power industries, improve lives, and drive the next wave of innovation.
- Technology: University research helps industries build faster, safer, and more precise devices.
- Medicine: Doctors rely on these discoveries to treat patients, save lives, and push medical science forward.
- Future Innovation: Every breakthrough paves the way for the next—transforming how we live, work, and thrive.
But research labs do more than advance science—they train the next generation of pioneers. With federal support, young scientists gain access to world-class mentors, cutting-edge technology, and the knowledge to tackle what seems impossible: curing diseases, solving global challenges, and shaping the future.
Without this investment, progress stalls. The discoveries of tomorrow depend on the support we give today.
How does research funding work?
Research funding comes in two essential parts:
- Direct Costs cover the scientists, lab supplies, equipment, and travel needed to conduct groundbreaking studies.
- Facilities & Administrative (F&A) Costs support the backbone of research—keeping labs running, maintaining critical research facilities, and ensuring safety and compliance.
What are facilities & administrative costs?
Facilities and Administrative (F&A) costs refer to the infrastructure and operational costs necessary for an institution to support research. These costs are not easily linked to an individual research project. F&A costs are sometimes called indirect or overhead costs.
Examples of F&A costs include reimbursing for portions of:
- Space for research activities, including state-of-the-art research labs
- Compliance support (e.g., human subject protections, export control, research security)
- Personnel to support accounting and administration
- High-speed data processing
- Library resources
- IT services
- Utilities
Why does the federal government cover F&A costs, and not universities
F&A costs are research costs. Universities and the federal government have a long-standing and successful partnership that grew out of World War II. The federal government relies on universities to conduct research in the national interest. This includes research aimed at meeting specific national goals such as health and welfare, economic growth, and national defense. Performing research on behalf of federal agencies incurs a variety of expenses that would not otherwise exist for universities. Universities – not the federal government – assume the risk of building the necessary infrastructure to support this research in anticipation that their research faculty will successfully compete for federal research grants and thus the university will be reimbursed for a part of the associated infrastructure costs. To learn more about the importance of F&A funding, visit this resource from the American Association of Universities.
What is the lifecycle of a breakthrough?
Breakthroughs made possible through federal funding have a life far beyond the lab where a discovery is made. The advances developed by university researchers are used by industry to make technological devices faster, more accurate and more safe. They are used by doctors to offer relief to patients and save lives. They are used by other researchers to make new, more game-changing breakthroughs possible. These scientific advances are the essential building blocks of modern life, allowing us to live longer, fuller and healthier lives.
How could the next generation of scientists be impacted by cuts to research?
Research labs at universities are not only developing treatments and advancing science, they are the training grounds for the next generation of researchers – the scientists who will one day accomplish what now feels out-of-reach, inconceivable feats like discovering a cure to cancer or eliminating food insecurity. Through federally funded research, these scientists have access to mentors at the top of their field, to technology that is so advanced it can accomplish tasks once thought impossible and to ideas and methods that will fuel their future discoveries.


